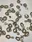

Dijes para decorar tu bombilla!
Son de acero y elásticos por lo que podes ponersela a la bombilla que te guste.
El stock que tenemos es variado por lo que si seleccionas este producto, nos comunicaremos para ofrecerte y que elijas el que mas te guste dentro de nuestro stock!